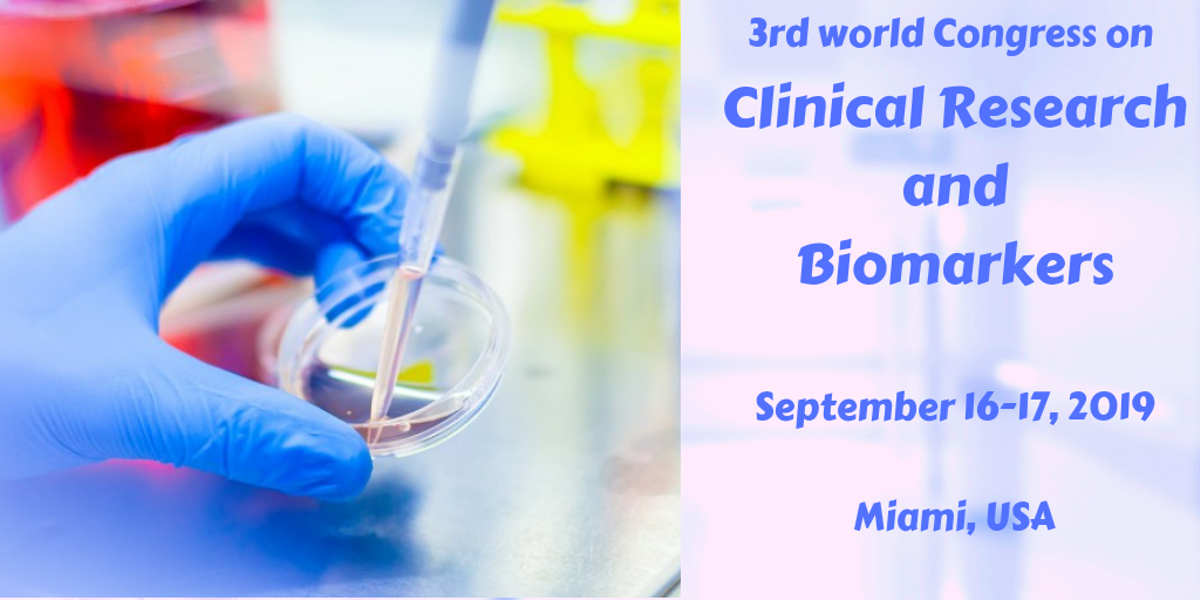
clinical_biomarkers_2019.png

In the determination of safety and effectiveness of medications, devices, diagnostic products and treatments Clinical Research plays a major role. From a naturally occurring molecule or gene, we can identify a particular pathological or physiological process. Those naturally occurring substances are Biomarkers. These two vast Combinations emerge into Clinical Research and Biomarkers Congress, which provides you a vast platform to share and gain knowledge among various people all over the world. We welcome Scientists, Health Practitioners, Speakers, Exhibitors, Research Fellows, Students and Delegates all over the world to attend our Congress.
The cultural, economic, and financial center of South Florid
Nearby
-
0.16 miles
-
0.17 miles
-
0.22 miles
-
0.23 miles
-
0.27 miles